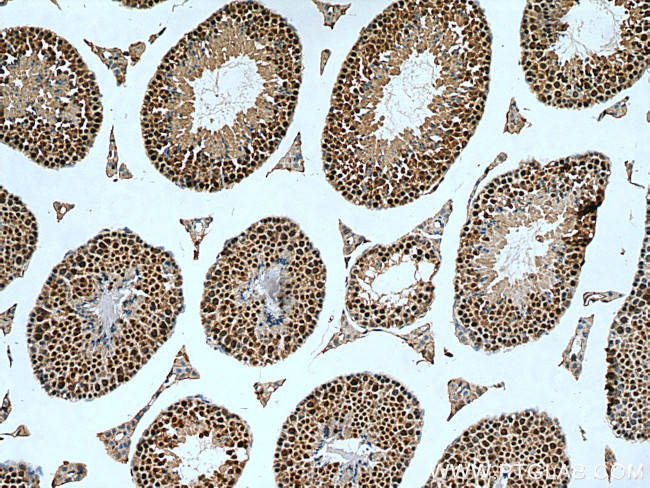
C20orf11 Antibody in Immunohistochemistry (Paraffin) (IHC (P))

Search
Proteintech
C20orf11 Polyclonal Antibody
{{$productOrderCtrl.translations['antibody.pdp.commerceCard.promotion.promotions']}}
{{$productOrderCtrl.translations['antibody.pdp.commerceCard.promotion.viewpromo']}}
{{$productOrderCtrl.translations['antibody.pdp.commerceCard.promotion.promocode']}}: {{promo.promoCode}} {{promo.promoTitle}} {{promo.promoDescription}}. {{$productOrderCtrl.translations['antibody.pdp.commerceCard.promotion.learnmore']}}
产品信息
24479-1-AP
种属反应
已发表种属
宿主/亚型
分类
类型
抗原
偶联物
形式
浓度
规格
纯化类型
保存液
内含物
保存条件
运输条件
产品详细信息
Immunogen sequence: MSYAEKPDE ITKDEWMEKL NNLHVQRADM NRLIMNYLVT EGFKEAAEKF RMESGIEPSL DLETLDERIK IREMILKGQI QEAIALINSL HPELLDTNRY LYFHLQQQHL IELIRQRETE AALEFAQTQL AEQGEESREC LTEMERTLAL LAFDSPEESP FGDLLHTMQR QKVWSEVNQA VLDYENREST PKLAKLLKLL LWAQNELDQK KVKYPKMTDL SKGVIEEPK (1-228 aa encoded by BC032120 )
靶标信息
TWA1 was identified through a two hybrid-associated protein screen with RanBPM. TWA1 is well conserved through evolution and is localized within the nucleus. It interacts with RanBP9 and comprises a protein complex with RanBPM and Muskelin. TWA1 was found to possess the LisH-CTLH motif which is detected in proteins involved in microtubule dynamics, cell migration, nucleokinesis and chromosome segregation. These functions overlap with functions suggested for the RanGTPase cycle. Recent findings suggested that there is an as yet uncovered function of the RanGTPase cycle.
仅用于科研。不用于诊断过程。未经明确授权不得转售。
生物信息学
蛋白别名: BWK-1; Bwk1 leukemia-related; GID complex subunit 8 homolog; Glucose-induced degradation protein 8 homolog; protein C20orf11; protein C20orf11 homolog; Twa1; two hybrid associated protein 1; two hybrid associated protein No. 1 with RanBPM; Two hybrid-associated protein 1 with RanBPM; unnamed protein product
基因别名: 2310003C23Rik; 4833420G11Rik; AI451474; Bwk1; C20orf11; GID8; TWA1
UniProt ID: (Human) Q9NWU2, (Mouse) Q9D7M1
Entrez Gene ID: (Human) 54994, (Mouse) 76425, (Rat) 296466